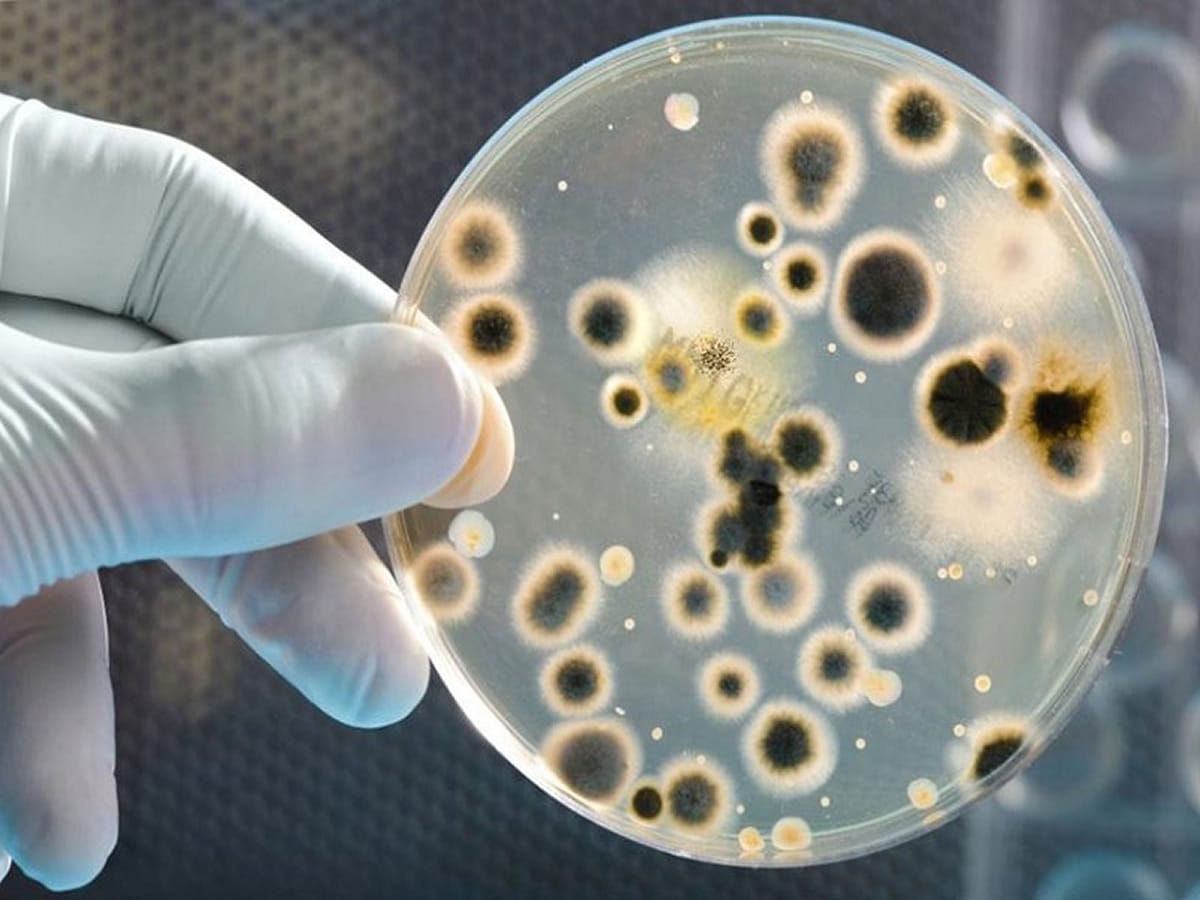

بیماری های مقاربتی یا آمیزشی در زنان و مردان

بیماریهای مقاربتی به بیماریهایی گفته میشود که از طریق تماس جنسی از فردی به فرد دیگر منتقل میشود. این بیماریها در زنان و مردان علائم مختلفی دارند و از طریق رابطه جنسی واژینال، مقعدی و یا دهانی از فردی به فرد دیگر منتقل میشوند.
لازم به ذکر است که وقتی شخصی مبتلا به یک بیماری مقاربتی باشد میتواند آن را از راه خون و شیردهی هم به افراد دیگر منتقل کند؛
بنابراین شاید بهتر است بگوییم دلیل اصلی انتقال بیماریهای مقاربتی تماس جنسی است. اما از راههایی مانند سوزن آلوده و شیردهی هم ممکن است انتقال بیماری صورت بگیرد. در ادامه به معرفی چند نوع بیماری مقاربتی شایع در زنان و مردان میپردازیم و برخی از علائم آنها را بررسی خواهیم کرد.
علائم بیماری مقاربتی در زنان و مردان
اگر چه احتمال وجود و انتقال بیماریهای مقاربتی بدون علامت هم وجود دارد اما برخی از این بیماریها در زنان و مردان علائم خاصی ایجاد میکنند. شایعترین علائم بیماریهای مقاربتی یا آمیزشی عبارتند از:
- احساس ناراحتی، سوزش و درد در حین رابطه جنسی یا دفع ادرار
- وجود زخمها، برآمدگیها و خارش و سوزش ناحیه تناسلی
- احساس تورم و درد در بیضهها در آقایان
- خونریزی غیر معمول و یا ترشحات غیر عادی از واژن خانمها
- ترشحات غیر معمول از اندام تناسلی در مردان و زنان
معرفی چند بیماری مقاربتی شایع
برخی از شایعترین بیماریهای مقاربتی عبارتند از:
کلامیدیا
کلامیدیا یک بیماری باکتریایی و مقاربتی شایع در زنان و مردان است که در بیشتر موارد فاقد علامت خاصی است. کلامیدیای مزمن میتواند علائمی مانند درد در زیر شکم، ترشحات زرد و سبز رنگ از اندامهای تناسلی زنانه و مردانه و نیز احساس درد و ناراحتی در حین رابطه جنسی و دفع ادرار را ایجاد کند. در صورت عدم درمان و پیشرفت این بیماری ممکن است به عفونتهای حاد در بیضهها، پروستات و… تبدیل شود و عوارضی نظیر بیماریهای التهابی لگن و ناباروری را به دنبال داشته باشد.

ویروس پاپیلومای انسانی HPV
این بیماری ویروسی میتواند از طریق رابطه جنسی یا تماس نزدیک پوست به پوست منتقل شود. ویروس HPV سویههای مختلفی دارد که علائم متفاوتی را ایجاد میکنند. شایع ترین علامتهای این بیماری شامل وجود زخمها و زگیلها در نواحی تناسلی یا دهان و گلو است. برخی از سویههای این بیماری ممکن است باعث ایجاد سرطانهایی مانند سرطان دهانه رحم، سرطان رکتوم، سرطان واژن و اندام جنسی مردانه شوند.
سیفیلیس
یک عفونت باکتریایی است که معمولا در مراحل اولیه علامتی ندارد. اولین علامت سیفیلیس یک زخم گرد و کوچک سفید رنگ است. این بیماری ممکن است واژن، مقعد یا دهان را درگیر کند و بدون ایجاد درد به شدت عفونی شود. سیفیلیس در حالت مزمن میتواند دارای علائمی نظیر بثورات جلدی، تب، سردرد، دردهای مفصلی و کاهش وزن باشد.
ایدز
ایدز نوعی بیماری ویروسی پیشرفته است که با تضعیف سیستم ایمنی بدن احتمال ابتلا به سایر بیماریهای ویروسی، باکتریایی و سرطانها را افزایش میدهد. این بیماری میتواند از طریق تماس جنسی، خونی یا شیردهی منتقل شود.
سوزاک
سوزاک نیز یک بیماری مقاربتی باکتریایی است. این بیماری در مراحل اولیه علائم خاصی ندارد اما در صورت داشتن علائم میتواند علائمی نظیر ترشحات غیر عادی از دستگاه تناسلی زنانه یا مردانه، درد در حین رابطه جنسی و دفع ادرار، تکرر ادرار و… را شامل شود. در صورت عدم درمان به موقع ممکن است سوزاک باعث عفونت پروستات، بیضه، بیماریهای لگنی و ناباروری شود.
تبخال
ویروس هرپس سیمپلکس (HSV) که به صورت عامیانه تبخال خوانده میشود هم یکی دیگر از بیماریهایی است که میتواند از طریق روابط جنسی انتقال یابد. HSV-1 و HSV-2 سویههای ویروس هرپس سیمپلکس هستند که از طریق مقاربت منتقل میشوند. HSV-1 همان تبخال دهانی است که در مواقع سرماخوردگی و… ایجاد میشود و میتواند از طریق رابطه جنسی دهانی به ناحیه تناسلی هم انتقال یابد.
در مقابل Hsv2 در درجه اول در ناحیه تناسلی ایجاد تبخال میکند. علامت اصلی تبخال، تاول و زخمهای ملتهب است. در تبخال تناسلی این زخمها در اطراف و داخل ناحیه تناسلی ایجاد میشوند. شایعترین علامت تبخال، زخمهای تاولدار است. در موارد تبخال دستگاه تناسلی، این زخمها در داخل یا اطراف دستگاه تناسلی ایجاد میشوند. در تبخال دهانی، آنها در دهان یا اطراف آن ایجاد میشود. زنان مبتلا به تبخال تناسلی در صورت بازداری میتوانند این زخمها را به جنین خود منتقل کنند.
سایر بیماریهای مقاربتی
شمار بیماریهای مقاربتی کشف شده روز به روز در حال افزایش است.
برخی از بیماریهای مقاربتی که شیوع کمتری دارند عبارتند از:
- شانکروئید
- شپش تناسلی
- لنفوگرانولوما ونروم
- گرانولوم مغبنی (اینگوینال)
- زگیل تناسلی آبکی یا ولوسکوم کانتوژیوزوم
- بیماری مقاربتی گال تناسلی
سخن پایانی
در این گفتار اطلاعاتی پیرامون انواع بیماریهای مقاربتی و علائم شایع آنها ارائه شد. این بیماریها بیشتر از طریق تماس جنسی محافظت نشده منتقل میشوند و در صورت عدم درمان به موقع ممکن است مشکلات جدی برای فرد به وجود بیاورند و حتی منجر به مرگ شوند. خودداری از روابط جنسی محافظت نشده و سبک زندگی سالم میتوانند تا حد زیادی از ابتلا به این بیماریها پیشگیری کنند. همچنین تشخیص سریع و پیگیری درمان میتواند این بیماریها را در همان مراحل اولیه خنثی کند و از پیشرفت آنها جلوگیری کند.
سوالات متداول
راه های انتقال بیماری های مقاربتی و آمیزشی چیست؟
این بیماریها در زنان و مردان علائم مختلفی دارند و از طریق رابطه جنسی واژینال، مقعدی و یا دهانی از فردی به فرد دیگر منتقل میشوند.
چند نوع بیماری مقاربتی داریم؟
1. کلامیدیا
2. ایدز
3. تبخال
4. بیماری پاپیلومای
5. سیفیلیس
بیماری سوزک چیست؟
سوزاک نیز یک بیماری مقاربتی باکتریایی است. این بیماری در مراحل اولیه علائم خاصی ندارد اما در صورت داشتن علائم میتواند علائمی نظیر ترشحات غیر عادی از دستگاه تناسلی زنانه یا مردانه، درد در حین رابطه جنسی و دفع ادرار، تکرر ادرار و… را شامل شود.